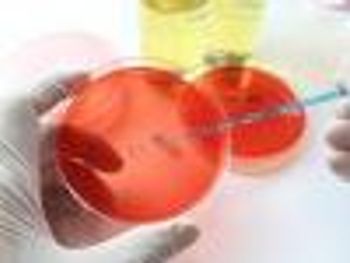

New findings demonstrating differing mechanisms may contribute to a better understanding of acquired resistance to combination drug treatment in cancer.
New findings demonstrating differing mechanisms may contribute to a better understanding of acquired resistance to combination drug treatment in cancer.

High body mass index linked to 10 types of cancer, including cancers of the breast, bowel, esophageal, and womb.

EnvisionRx and Walgreens collaboration creates largest 90-day retail maintenance medication network in the United States.

Partnership between Walgreens and EnvisionRx focuses on improving outcomes and adherence in patients with chronic conditions.

People of color who are underrepresented in multiple sclerosis clinical trials need to be engaged.

Mutation prevents the development of fibrosis in disease that mimics inflammatory bowel disease.

Risk of developing mental health issues were found to be lower in chronic obstructive pulmonary disease patients who are more active.

Mark A. Vineis, vice president of Specialty Pharmacy of Cardinal Health, discusses how the increased interest of the federal government in escalating drug prices may impact specialty pharmacy.

Top news of the day from across the healthcare landscape.

Top news of the day from across the health care landscape.

Chemotherapy combined with immunotherapy found to destroy dormant cancer cells.

Chemotherapy alone leaves behind dormant cells, but when combined with immunotherapy, it can destroy most of the dormant cells.

HIF-2 inhibitors may be better tolerated and more effective in kidney cancer.

HIV can increase hospitalization for mental health issues compared with the general population.

Inhibiting immune cells’ oxygen-sensing capability prevented lung metastasis in mice.

The median charge of treatment for a 6-day hospital stay totals $37,000 in young cancer patients in need of stem cell transplants.

Paul LeVine, vice president of Analytic Services at TrialCard, discusses how specialty pharmacies can use patient feedback surveys to improve treatment outcomes.

Achieving global elimination of the virus starts with illicit drug users accessing curative hepatitis C virus treatments.

Insight into the inner complexities of HIV and cytotoxic T lymphocyte evolution raise hopes for HIV cure.

Chromosomal instability may be a potential biomarker for cancer prognosis.

Top news of the day from across the health care landscape.

The revolutionary CRISPR/Cas9 gene editing tool can target and inactivate cancer mutations, leading to more personalized therapies for patients.

Autumn Bagwell, PharmD, BCPS, clinical pharmacist at Vanderbilt Specialty Pharmacy, discusses the components of an effective patient management program to optimize adherence.

Oral supplements may boost current asthma treatments to significantly reduce the risk for asthma attacks.

Top news of the day from across the health care landscape.

New evidence suggests that oral supplements taken with asthma treatments significantly reduce the risk for asthma attack.

Preventative strategies necessary to reduce hospital admissions resulting from cancer treatments, medical complications, accidents, and self-harm.

Selective manipulation of an enzyme can stop cancer cachexia.

Vitamin A metabolite in the gut kills off cancer cells.

Immunotherapy able to kill triple-negative breast cancer cells via two-pronged strategy.